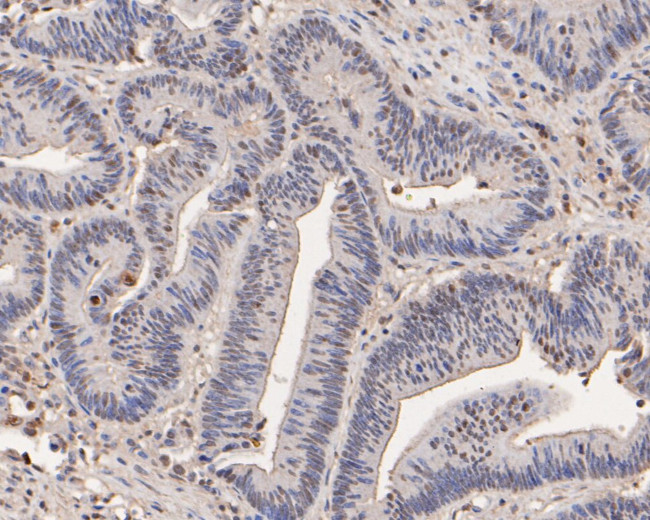
RBBP7 Antibody in Immunohistochemistry (Paraffin) (IHC (P))

Search
Huabio
RBBP7 Polyclonal Antibody
{{$productOrderCtrl.translations['antibody.pdp.commerceCard.promotion.promotions']}}
{{$productOrderCtrl.translations['antibody.pdp.commerceCard.promotion.viewpromo']}}
{{$productOrderCtrl.translations['antibody.pdp.commerceCard.promotion.promocode']}}: {{promo.promoCode}} {{promo.promoTitle}} {{promo.promoDescription}}. {{$productOrderCtrl.translations['antibody.pdp.commerceCard.promotion.learnmore']}}
图: 1 / 3
RBBP7 Antibody (HA500155) in IHC (P)



产品信息
HA500155
种属反应
宿主/亚型
分类
类型
抗原
偶联物
形式
浓度
规格
纯化类型
保存液
内含物
保存条件
运输条件
靶标信息
This protein is a ubiquitously expressed nuclear protein and belongs to a highly conserved subfamily of WD-repeat proteins. It is found among several proteins that binds directly to retinoblastoma protein, which regulates cell proliferation. The encoded protein is found in many histone deacetylase complexes, including mSin3 co-repressor complex. It is also present in protein complexes involved in chromatin assembly. This protein can interact with BRCA1 tumor-suppressor gene and may have a role in the regulation of cell proliferation and differentiation.
仅用于科研。不用于诊断过程。未经明确授权不得转售。
篇参考文献 (0)
生物信息学
蛋白别名: G1/S transition control protein-binding protein; G1/S transition control protein-binding protein RbAp46; Histone acetyltransferase type B subunit 2; Histone-binding protein RBBP7; Nucleosome-remodeling factor subunit RBAP46; RBBP-7; RBBP7; Retinoblastoma-binding protein 7; Retinoblastoma-binding protein p46; retinoblastoma-binding protein RbAp46; unnamed protein product
基因别名: AA409861; AI173248; AU019541; BB114024; mRbAp46; RBAP46; RBBP7; SPGFX9
UniProt ID: (Human) Q16576, (Mouse) Q60973
Entrez Gene ID: (Human) 5931, (Mouse) 245688